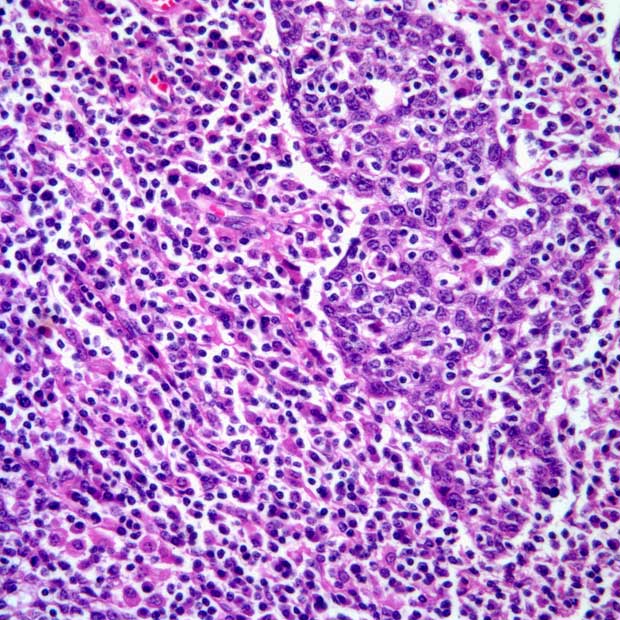

Adjuvant Chemo Does Not Improve Outcomes in Locally Advanced Cervical Cancer
Findings from the phase 3 OUTBACK trial show that following standard cisplatin-based chemotherapy with adjuvant chemotherapy resulted in increased toxicity among patients with cervical cancer.
The use of adjuvant carboplatin and paclitaxel chemotherapy following standard cisplatin-based chemoradiotherapy did not improve outcomes over chemoradiotherapy alone among patients with locally advanced cervical cancer, according to data from the phase 3 OUTBACK trial (NCT01414608).
"The planned addition of 4 cycles of paclitaxel plus carboplatin following chemoradiotherapy with cisplatin for locally advanced cervical cancer did not improve OS or PFS," according to the authors of the phase 3 OUTBACK trial.
The 5-year overall survival (OS) rates were 72% (95% CI, 67%-76%) in the adjuvant chemotherapy group, and 71% (95% CI, 66%-75%) in the chemoradiotherapy-alone group (Hazard ratio [HR], 0.90; 95% CI, 0.70-1.17; P = .81). There were 105 and 116 deaths in each respective group. The median follow-up as of data cutoff was 60 months (Interquartile range [IQR], 45-65).
“The planned addition of 4 cycles of paclitaxel plus carboplatin following chemoradiotherapy with cisplatin for locally advanced cervical cancer did not improve [OS] or progression-free survival [PFS],” the investigators wrote. “The survival results are somewhat surprising given the suggestive evidence for adjuvant cytotoxic therapy in this same patient population in previous trials. This academic study, with its large sample size, mature follow-up, and multi-national accrual, provides opportunities to generate hypotheses for the results seen.”
The multicenter, open-label, phase 3 OUTBACK trial assessed outcomes across 919 patients who enrolled between April 15, 2011 and June 26, 2017, with 456 in the chemoradiotherapy-alone group and 463 in the adjuvant chemotherapy group.
The primary end point was OS at 5 years. Secondary end points included PFS at 3 and 5 years, safety, and health-related quality of life [HRQOL].
Patients had a median age of 46 years (IQR 37-55). Demographic characteristics were relatively balanced between the 2 treatment groups. In the intent-to-treat (ITT) population, 72% of patients were White, 13% were Black or African American, 6% were Asian, 3% were Aboriginal or Pacific islander, and 6% were other races. Roughly half of patients in each group reported no history of smoking; the remainder had a current, former, or unknown smoking habit.
Overall, 79% of the control group and 83% of the experimental group had squamous cell carcinoma. Additionally, 75% and 73% had an ECOG performance status of 0, respectively.
All patients underwent standard external beam radiotherapy to the pelvis plus brachytherapy, accompanied by intravenous cisplatin at a dose of 40 mg/m² once weekly for 5 weeks. The omission of the cisplatin component, or a dose reduction to 30 mg/m², was allowed in the case of prespecified AEs.
Additionally, patients in the experimental group received 4 cycles of adjuvant chemotherapy consisting of intravenous carboplatin (areas under the receiver operator curve [AUC] 5 over 1 hour) and intravenous paclitaxel at a dose of 155 mg/m² over 3 hours, administered on day 1 of each 21-day cycle. These dosages could be reduced or delayed for up to 2 weeks.
PFS outcomes mirrored OS outcomes, with a 5-year PFS of 63% (95% CI, 58%-68%) in the adjuvant chemotherapy group vs 62% (95% CI, 57%-66%) in the chemoradiotherapy-alone group (HR, 0.86; 95% CI, 0.69-1.08; 95% CI, 0.58). Moreover, the 5-year cumulative incidence of cervical cancer-specific death was 21% (95% CI, 17%-26%) in the experimental group vs 24% (95% CI, 20%-28%) in the control group (P = .21).
Additionally, clinically significant grade 3/4 adverse effects (AEs) occurred more frequently in the adjuvant chemotherapy group. These AEs included decreased neutrophils in 20% of patients in the adjuvant chemotherapy group vs 8% in the chemoradiotherapy-alone group, and anemia in 18% and 8%, respectively.
AEs of grade 3 or higher occurred in 81% of patients in the adjuvant chemotherapy group vs 62% in the chemoradiotherapy-alone group (P <.0001).
Investigators also reported worse mean QLQ-C30 global health status and QOL scores in the adjuvant chemotherapy group compared with the chemoradiotherapy-alone group in the first 3 to 6 months after completion of chemoradiotherapy. The scores became similar at 12 to 36 months after completion.
“Future studies should focus on [patients] with high-risk disease who have the most to gain from additional treatment, and avoid over-treating patients who do well with standard of care treatments,” the investigators concluded. “Subsequent translational research from the OUTBACK trial will be important to improve understanding of which groups of patients are most at risk of disease recurrence.”
Reference
Mileshkin LR, Moore KN, Barnes EH, et al. Adjuvant chemotherapy following chemoradiotherapy as primary treatment for locally advanced cervical cancer versus chemoradiotherapy alone (OUTBACK): an international, open-label, randomised, phase 3 trial. Lancet Oncol. Published online April 17, 2023. doi:10.1016/S1470-2045(23)00147-X